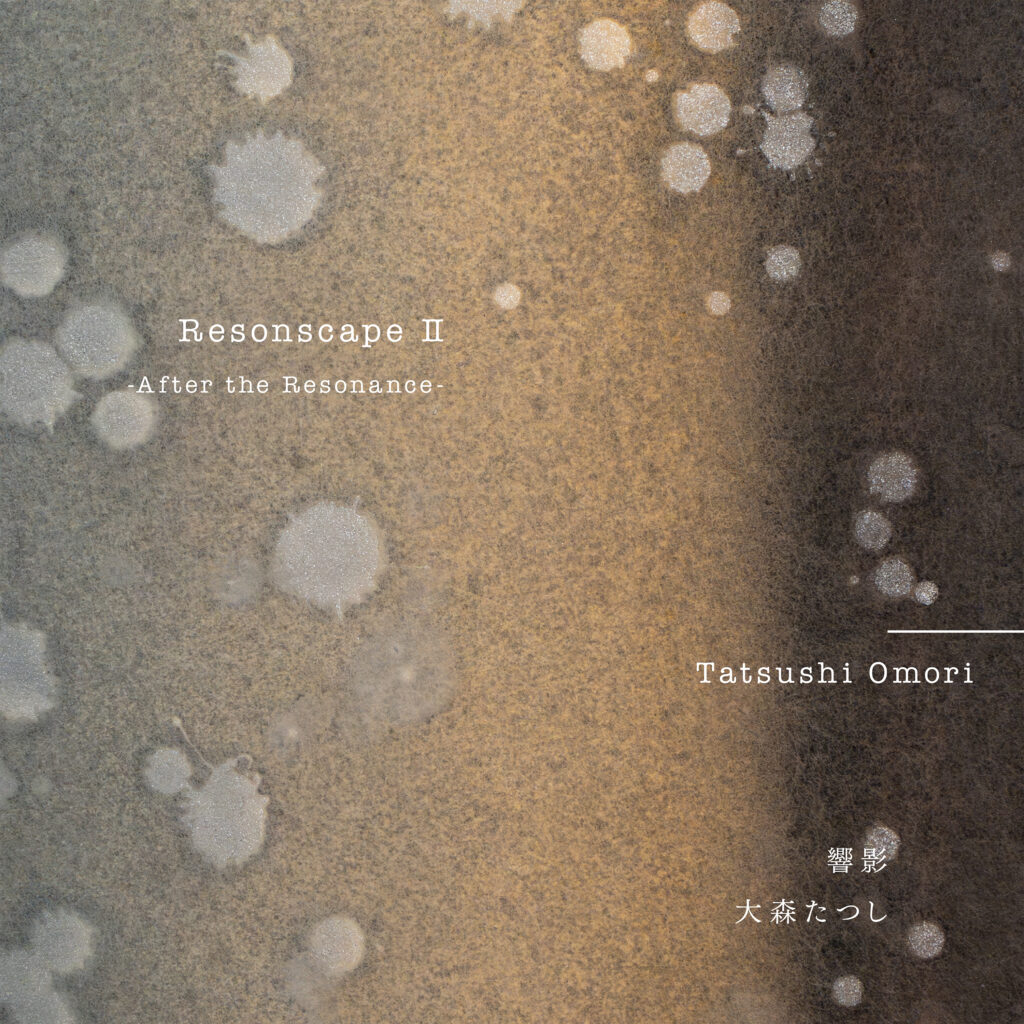

Resonscape
Resonscape I — 静寂に宿る響き
Resonscape II ― 響影
大森たつし
響き 【レゾナンス】の、その先へ。
Resonscape は、マリンバの響きを「音」ではなく風景として記録するシリーズです。
打撃によって生まれながら、決して打撃的ではないマリンバの音。
その音が空間に触れ、広がり、やがて静寂へと溶けていく過程そのものを、極めて解像度の高い空間音響システムによって捉えました。
「Resonscape I — 静寂に宿る響き」 では、響きが沈黙へと還っていく時間を見つめ、
「Resonscape II ― 響影」では、その響きが消えたあとに残る空気や気配に耳を澄ます。
演奏・空間・録音が分かちがたく結びついたとき、音楽は出来事ではなく、そこに「在り続ける風景」となります。
Resonscape は、聴くという行為そのものを問い直す、静かな連作なのです。
録音空間と演奏について
本作は、二つの異なるアルバムが、それぞれ異なる空間で録音された対になる作品です。
いずれの録音においても、極めて解像度の高い空間音響システムを用い、音そのものだけでなく、音が生まれ、空間に触れ、消えていくまでの時間と気配を含めて収録しています。
その目的は、音を「大きく」録ることでも、響きを「美しく加工」することでもありません。
音と空間が関わり合う、その過程そのものを音楽として記録することにありました。


最後の音が消えたあと、聴く前とは少しだけ違う静けさが訪れます。
それは沈黙ではなく、音を通過した時間が残した痕跡のようなものです。
Resonscape II ― 響影 《After the Resonance》で辿ってきたのは、
音が鳴る瞬間よりも、音が役割を終えていく過程でした。
響きは消えながら、聴く意識の中に静かに形を残していきます。
このアルバムが、音楽を聴き終えたあとにも、ほんのしばらく耳を澄ませたくなるような、
そんな時間をもたらすことができたなら幸いです。
大森たつし
Resonscape
レゾンスケープ
大森たつし
収録日・場所:2024年5月16日〜19日 八ヶ岳やまびこホール
本作品は、Dolby Atmos版およびステレオ版を各種音楽サブスクリプション・サービスよりお楽しみいただけます。
※ご試聴いただける各種音楽サブスクリプション・サービスは、配信ディストリビューターの都合により変更になる場合がございます。
Resonscape I — 静寂に宿る響き
Resonscape I ーResonance in Silence
「Resonance in Silence — 静寂に宿る響き」は、山梨県北杜市にある 八ヶ岳やまびこホール にて収録されました。
このホールの響きは、音が生まれた瞬間から遠くへと自然に広がり、余韻が長く、柔らかく空間に溶け込んでいきます。
高解像度の空間収録によって、マリンバの音は輪郭を誇張されることなく、空気の層の中に静かに置かれていきます。
演奏では、音が鳴っている時間以上に、音が消えていく過程に意識を向けました。
この空間は、静寂へと還っていく響きを音楽として聴かせてくれる場所です。

Track List
| 1 | 静寂 | カール・ジェンキンス |
| 2 | リズム・ソング | ポール・スマッドベック |
| 3 | アメイジング・グレイス | 作曲者不詳 |
| 4 | タンティ・アンニ・プリマ | アストル・ピアソラ |
| 5 | 鏡の中の鏡 | アルヴォ・ペルト |
演奏:大森たつし(マリンバ)、 福井真菜(ピアノ)(Tr.3–5)
Resonscape II ― 響影
Resonscape II ーAfter the Resonance
「After the Resonance ― 響影」は、山梨県の清里にある 萌木の村・Hall of Hallsにて録音されました。
こちらの空間では、音はより近く、具体的に立ち上がります。
アタック、倍音、減衰といった要素が明瞭で、タッチや間の違いが、そのまま音楽の表情として現れます。
高い解像度を持つ録音システムは、演奏の細部だけでなく、音と音のあいだに漂う空気や緊張感までも克明に捉えています。
そのため演奏では、残響に委ねるのではなく、沈黙や間を、演奏者自身が形づくることを重視しました。
響きの「あと」に残る気配——
それこそが、このアルバムの中心にあります。
Track List
| 1 | Land | 村松崇継 |
| 2 | 2つのアラベスク, L. 66: 第1曲. アンダンティーノ・コン・モート | クロード・ドビュッシー |
| 3 | ウッドゥン・ミュージック | リッチ・オメーラ |
| 4 | スリープ | エリック・ウィテカー |
演奏:大森たつし(マリンバ)、 神原瑶子(マリンバ)(Tr.2–4)

大森たつし
Tatsushi Omori
(マリンバ)
神奈川県横須賀市出身。洗⾜学園⾳楽⼤学卒業。1999年Marimba & Percussion Duo「Cheer’s」でデビュー。2001年より⽥辺製薬主催「マリンバソロリサイタル」を銀座⼗字屋にて5回にわたり開催。2004年「⽇本領事館主催コンサート」(スイス)、2005年「英国王⽴⾳楽院主催コンサート」(イギリス)にて公演。2003年-2009年、American Wind Symphony Orchestraの客員打楽器奏者として新曲初演、ソロ演奏、室内楽、CDレコーディングを⾏う。200回を超える海外公演の他、国内では「⽂化賞授賞式記念式典」「愛⼦様御⽣誕祝賀コンサート」、オーケストラとの共演など公演多数。2023年現在、テレビ出演、ラジオ番組のパーソナリティー、様々なCD・CM・映画⾳楽のレコーディングに参加、SEKAI NO OWARI・槇原敬之・元ちとせ・スキマスイッチ・⼭崎まさよし、KinKi Kids等のミュージシャンのサポート等、活動範囲を広げている。これまでに、世界初アンティークオルゴールとのコラボレーションCDアルバム「UTOPIA」と「UTOPIA 2」、マリンバとピアノデュオCD「Lumière」をリリース。
official website : tatsushiomori.com
YouTube: 「大森たつしチャンネル」

入交 英雄
Hideo Irimajiri
(RME Premium Recordings 音楽監督、エグゼクティブ・プロデューサー)
1956年生まれ。1979年九州芸術工科大学音響設計学、1981年同大学院卒。2013年残響の研究で博士(芸術工学)を取得。1981年(株)毎日放送入社。映像技術部門、音声技術部門、ホール技術部門、ポスプロ部門、マスター部門を歴任。2017年より(株)WOWOWにてイマーシブオーディオの制作技術開発、事業開発。2025年入交イマーシブオーディオ研究所を立ち上げ「ならまちスタジオ」を開設。RME Premium Recordings 音楽監督就任。
1987年、放送業界初となる高校野球サラウンド放送のプロジェクトに関わる。2005年より放送のラウドネス問題研究とARIB委員、民放連委員を通じて規格化に尽力。学生時代より録音活動を行い、特に4ch録音や空間音響について探求を重ね、現在では3Dオーディオ録音の技術開発と共に、精力的な制作や普及活動を行っている。
2021年 冨田勲「源氏物語交響絵巻」(プロ音楽録音賞イマーシブ部門 最優秀賞受賞)
2021年 ボブジェームス「Feel Like Making Live」UHD BD、2024年 MR.BIG 「The BIG Finish Live」UHD BD
また、個人的にも入間次朗の名前で音楽制作活動を行っており、花園高校ラグビーのオープニングテーマやPCゲームのロードス島戦記などを担当。
Recording Information
Recording Dates: May 16–19, 2024
Recording Location for Resonscape I: Yatsugatake Yamabiko Hall, Hokuto City, Yamanashi Prefecture
Recording Location for Resonscape II: Kiyosato Moeginomura Museum HALL of HALLS, Yamanashi Prefecture
Credits
General Producer: Seiji Murai (Synthax Japan)
General Music Director & Recording Engineer: Hideo Irimajiri (Irimajiri Immersive Audio Laboratory)
Marimba Performance & Album Curation: Tatsushi Omori
Piano Performance : Mana Fukui
Marimba Performance : Yoko Kamihara
Bösendorfer Tuning: Jun Terunuma
Web Producer: Takeshi Mitsuhashi (Onkeisha)
Venue Manager & Marketing Director: Kaori Terasawa (Synthax Japan)
Creative Director: Nao Masaki
Artist Paint: Ayana Mizuno
English Website Production
Producer: Takeshi Mitsuhashi (Onkeisha)
Programmer: Takeshi Mitsuhashi (Onkeisha)
Special Thanks
Joji Funaki, Sachiko Kawano, Kanji Murai (Genelec Japan)